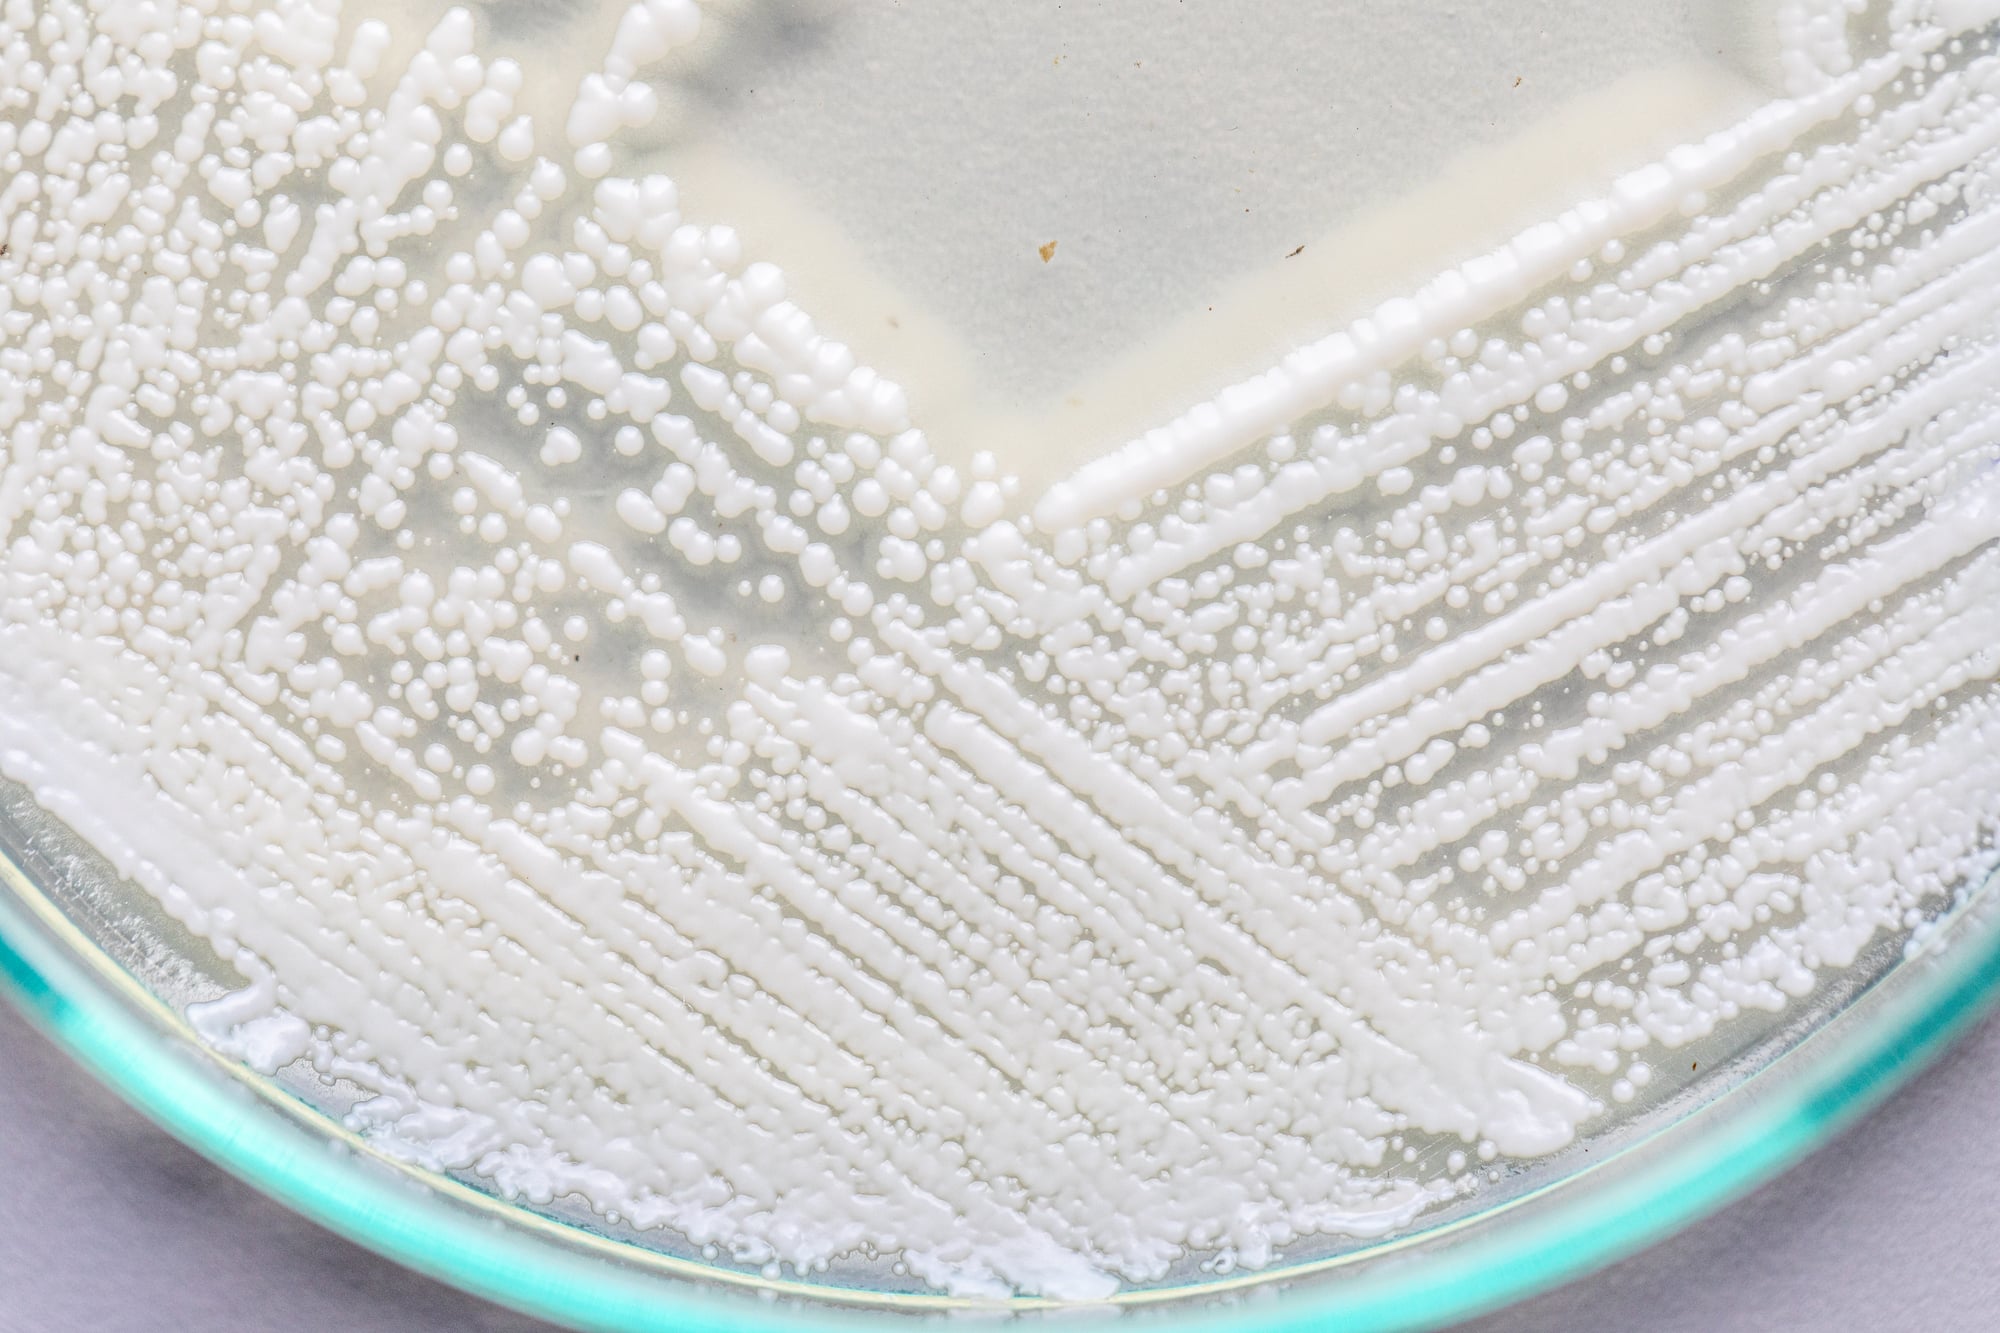

18 Mathematical Patterns Hidden in Everyday Objects
Mathematics isn’t just confined to textbooks and classrooms—it’s woven into the fabric of everything around us. From the coffee cup on your desk to the flowers in your garden, mathematical patterns create the structure and beauty we see every day.
These hidden formulas and sequences have been quietly organizing our world long before humans ever discovered them. Most people walk past these mathematical marvels without a second glance, but once you start noticing them, you’ll see math everywhere.
Here is a list of 18 mathematical patterns hidden in everyday objects.
Fibonacci Spirals in Pinecones

Count the spirals on a pinecone and you’ll discover they follow the famous Fibonacci sequence: 1, 1, 2, 3, 5, 8, 13, and so on. Most pinecones have exactly 8 spirals going one direction and 13 going the other, both consecutive Fibonacci numbers.
This pattern helps the pinecone pack its seeds as efficiently as possible, maximizing space while maintaining structural strength.
Hexagonal Patterns in Honeycomb

Bees are natural mathematicians who’ve solved one of geometry’s most efficient packing problems. Hexagons use the least amount of wax to create the maximum storage space, making them the perfect shape for honey storage.
The 120-degree angles in each hexagon also provide incredible structural stability, which is why engineers use hexagonal patterns in everything from airplane wings to building materials.
Like Go2Tutors’s content? Follow us on MSN.
Golden Ratio in Credit Cards

Your wallet contains a perfect example of the golden ratio, approximately 1.618 to 1. Standard credit cards measure 3.375 inches by 2.125 inches, creating a rectangle with proportions that match this ancient mathematical relationship.
This ratio appears pleasing to the human eye and shows up in art, architecture, and design because our brains seem naturally wired to find it attractive.
Parabolic Curves in Satellite Dishes

The curved shape of satellite dishes follows a precise mathematical formula called a parabola. This curve has a special property where signals hitting anywhere on its surface bounce directly toward a single focal point, concentrating weak signals from space into a strong, clear reception.
The same parabolic principle works in car headlights, focusing light into a powerful beam that illuminates the road ahead.
Logarithmic Spirals in Seashells

Nautilus shells grow in a logarithmic spiral that maintains the same proportional shape as the shell gets larger. Each new chamber is exactly the same shape as the previous one, just scaled up by a constant factor.
This mathematical growth pattern allows the nautilus to maintain perfect balance and buoyancy as it adds new living space throughout its life.
Like Go2Tutors’s content? Follow us on MSN.
Fractal Patterns in Broccoli

Romanesco broccoli displays one of nature’s most striking fractal patterns, where each small cone looks exactly like the whole vegetable in miniature. This self-similar pattern repeats at multiple scales, following mathematical rules that create infinite complexity from simple repetition.
Regular broccoli and cauliflower show similar fractal branching, though less dramatically than their spiral cousin.
Sine Waves in Sound and Light

Every sound you hear and every color you see follows the mathematical pattern of sine waves. Music notes, radio signals, and light waves all oscillate in smooth, repetitive curves that can be described by trigonometric functions.
When you adjust the bass on your stereo, you’re literally manipulating the mathematical properties of these waves to change how they sound.
Exponential Growth in Bacterial Colonies
That moldy piece of bread in your kitchen demonstrates exponential growth, where numbers double at regular intervals. One bacterium becomes two, then four, then eight, following the mathematical pattern 2^n where n represents each generation.
This same exponential pattern explains compound interest in your savings account and why viral videos spread so rapidly across social media.
Like Go2Tutors’s content? Follow us on MSN.
Prime Number Distribution in Cicada Life Cycles

Periodical cicadas emerge every 13 or 17 years, both prime numbers that help them avoid predators with shorter life cycles. If cicadas emerged every 12 years, they’d encounter predators with 2, 3, 4, or 6-year cycles much more frequently.
By choosing prime number cycles, they minimize the mathematical overlap with other species, giving them a survival advantage that evolution has fine-tuned over millions of years.
Geometric Progressions in Russian Nesting Dolls

Matryoshka dolls demonstrate geometric sequences where each doll is a consistent fraction of the size of the one containing it. If each doll is 80% the size of the previous one, you can predict the exact dimensions of any doll in the set using exponential functions.
This mathematical relationship ensures that all the dolls fit together perfectly while maintaining their proportional appearance.
Catenary Curves in Hanging Chains

When you hang a chain or cable between two points, it naturally forms a catenary curve, which follows a specific mathematical equation involving hyperbolic functions. This isn’t the same as a parabola, though they look similar to the casual observer.
Engineers use catenary mathematics to design suspension bridges, power lines, and architectural arches that can support enormous weights safely.
Like Go2Tutors’s content? Follow us on MSN.
Tessellation Patterns in Floor Tiles

Bathroom and kitchen floors often display tessellations, where geometric shapes fit together perfectly without gaps or overlaps. Regular tessellations use identical shapes like squares, triangles, or hexagons, while semi-regular patterns combine different shapes following strict mathematical rules.
These patterns have fascinated mathematicians for centuries and appear in Islamic art, Roman mosaics, and modern graphic design.
Probability Distributions in Manufacturing

Every mass-produced item in your home, from screws to smartphone screens, demonstrates statistical distributions. Manufacturers use normal distribution curves to predict how many products will meet quality standards and how many might have defects.
The bell curve pattern shows up in everything from the weight of cereal boxes to the brightness of LED bulbs coming off assembly lines.
Polar Coordinates in Clock Faces

Clock faces represent one of the most familiar examples of polar coordinate systems, where position is defined by angle and distance from a central point. The hour and minute hands trace circular paths that can be described using trigonometric functions, making analog clocks perfect teaching tools for understanding rotational mathematics.
Digital clocks might be more precise, but analog faces make time’s circular nature visually apparent.
Like Go2Tutors’s content? Follow us on MSN.
Logarithmic Scales in Volume Controls

The volume knob on your stereo uses a logarithmic scale because human hearing perceives sound intensity logarithmically rather than linearly. Doubling the actual sound power doesn’t sound twice as loud to your ears, so audio equipment compensates by using mathematical curves that match how your brain processes sound.
This same logarithmic principle appears in earthquake measurements, pH scales, and photographic exposure settings.
Minimum Surface Area in Soap Bubbles

Soap bubbles automatically solve complex calculus problems by forming shapes with the minimum possible surface area for a given volume of air. A single bubble is always spherical because spheres have the smallest surface area-to-volume ratio of any three-dimensional shape.
When bubbles connect, they create more complex surfaces that still minimize total area, demonstrating mathematical optimization principles that engineers struggle to calculate.
Symmetry Groups in Wallpaper Patterns

Decorative wallpaper and fabric patterns follow strict mathematical rules called symmetry groups, with exactly 17 possible ways to create repeating patterns on a flat surface. These mathematical classifications include translations, rotations, reflections, and glide reflections that create visually appealing designs.
Every wallpaper pattern you’ve ever seen fits into one of these 17 mathematical categories, whether the designer knew it or not.
Like Go2Tutors’s content? Follow us on MSN.
Modular Arithmetic in Calendar Systems

Calendars use modular arithmetic, where numbers ‘wrap around’ after reaching a certain value. Days of the week repeat every 7 days, months cycle every 12, and hours reset every 24, creating mathematical patterns that help us organize time.
This same modular mathematics appears in computer programming, cryptography, and music theory, making calendar calculations more mathematically sophisticated than they initially appear.
The Hidden Language All Around Us

Mathematics isn’t an abstract concept created by scholars—it’s the fundamental language that describes how our universe organizes itself. These patterns existed long before humans discovered them, quietly shaping everything from the smallest pinecone to the largest architectural structures.
Recognizing these mathematical relationships helps us appreciate the elegant logic underlying seemingly random natural phenomena. The next time you encounter any of these everyday objects, you’ll know you’re looking at millions of years of mathematical evolution in action, proving that nature has always been the greatest mathematician of all.
More from Go2Tutors!

- 16 Restaurant Chains That Went Too Fast
- 12 Things Sold in the 80s That Are Now Illegal
- 15 Strange Things People Have Tried to Ban (And Failed)
- 16 Collectibles People Tossed Out Too Soon
- 17 Myths from Your Childhood That Were Actually Based on Real Things
Like Go2Tutors’s content? Follow us on MSN.